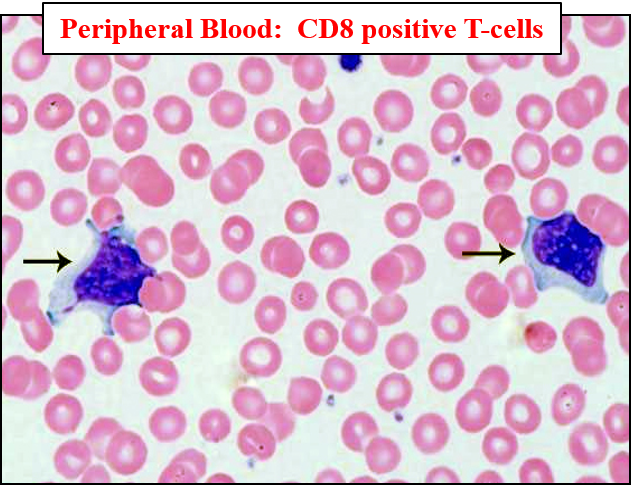

Left side is positive for what?
EBV - Monospot test (Heterphil test)
A patient comes to your clinic with tender lymph nodes, a fever of 102 F, enlarged tonsils, and a dull sound over the Traube’s space and lymphocytosis. Under a microscope, you see atypical lymphocytes that is indented by surrounding RBC’s (looks like a skirt).
What test would you do next?
What would you expect to see?
Patient may have mononucleosis from EBV. Do a heterphil test (monospot).
The left one is positive – red agglutination on a blue backround show presence of infectious mononucleosis heterphile antibodies.
In infectious mononucleosis, patients develop an antibody called ___ antibodies. These antibodies are not specific for EBV, but attach to sheet and horse ___s. The test shows the ability of the patients serum to ___ to the horse RBC. What would clumping mean?
Clumping means a posititve monospot test.
There are many false negatives in a monospot test. What would do you do if you still believe someone has mono?
What would you expect to see?
You can do a serological test to test for different antibodies.
In acute phase infectious mononucleosis, you can do an a IgM antibody test to measure the presence of viral capdi antigens of EBV (IgM-VCA).
VCA-IgM = IgM antibody to viral capsid antigen (__ acute, __ past)
VCA-IgG = IgG antibody to viral capsid antigen (__ acute, ___ past)
EA = Antibody to the EBV early antigen (__ acute, __ past)
EBNA = Antibody to EBV nuclear antigen (__ acute, __ past)
VCA-IgM = IgM antibody to viral capsid antigen (+ acute, - past)
VCA-IgG = IgG antibody to viral capsid antigen (+ acute, - past)
EA = Antibody to the EBV early antigen (+/- acute, - past)
EBNA = Antibody to EBV nuclear antigen (- acute, + past)
EBV induces a proliferation of __ in lymphoid tissue. When EBV infects these, they become transformed ___. They become large atypical cells with prominant ___ resembling malignant ___.
EBV ONLY INFECTS _____!!!
EBV induces a proliferation of LYMPHOCYTES in lymphoid tissue. When EBV infects these, they become transformed LYMPHOCYTES. They become large atypical cells with prominant NUCLEOLI resembling malignant LYMPHOCYTES.
EBV ONLY INFECTS B CELLS!!!
EBV is a type of HHV-___
4
EBV is transmitted by human contact, and frequently by kissing. It is ubiquitous and infects >__% people by age 25.
95%
Pathogenesis of EBV:
Initially, it affects the ___ epithelial cells, then spreads to underlying __ tissue (___ and __, where mature __ cells are infected.
EBV binds to the ___ B cell receptor, normally used for the ___ component of complemenet.
Pathogenesis of EBV:
Initially, it affects the oropharyngeal epithelial cells, then spreads to underlying lymphoid tissue (tonsils and adenoids, where mature B cells are infected.
EBV binds to the CD21 B cell receptor, normally used for the c3d component of complement.
Infection of B cells may take 1 of 2 forms:
Infection of B cells may take 1 of 2 forms:
People who lack B cells like in _____ disease, don’t have get infections of EBV.
X linked Agammaglobulinemia
Pathogenesis of EBV latentcy stage:
Pathogenesis of EBV latentcy stage:
EBV promotes __ cell proliferation, drives __ cell activation and prevents ___. It does this because it is living inside of _ cells, but on the other hand, it does not want to be killed by T cells, so it suppresses T cells. During latency phase, B cells divide and all __ cells will have EBV genome.
EBV promotes B cell proliferation, drives B cell activation and prevents apoptosis (via Bcl-2). It does this because it is living inside of B cells, but on the other hand, it does not want to be killed by T cells, so it suppresses T cells. During latency phase, B cells divide and all daughter cells will have EBV genome.
Ineffective __ cell response leads to uncontrolled __ cell proliferation and called __ cell malignancies!
Ineffective T cell response leads to uncontrolled B cell proliferation and called B cell malignancies!
Clinical findings of EBV in:
Clinical findings of EBV in:
What type of lymphocytes would you expect to see in a person infected with EBV?
Atypical lymphocytes that look like skirts.
Hemotologic findings in EBV:
one of the key features is absolute ___.
Absolute lymphocytosis > 4.0 x 103 mL (Range 10-30 x 103 mL)
Patients with EBV tend to have enlarged ___. On a stain, EBV looks ___.
lymphnodes/tonsils
black

IM Diagnosis in increasing order of specificity:
•Increasing order of specificity:
1.Atypical _____
•Characteristic ___ lymphocytes in the peripheral blood
•Increasing order of specificity:
1.Atypical lymphocytosis
•Characteristic atypical lymphocytes in the peripheral blood
HSV 1 + 2 - latency infection
Entry of site? ___ or ___
Causes: ___ ___ lesions
Establishes infections in innervated __ ___.
Replicates where? __ and __ membranes
Clinical presentations of;
HSV-1? ___, ___
HSV 2? ___ herpes
Reactivation may occur repeadetly with or without symptoms.
HSV 1 + 2 - latency infection
Entry of site? oropharynx or genitals
Causes: epidermal vesicular lesions
Establishes infections in innervated sensory neurons.
Replicates where? skin and mucus membranes
Clinical presentations of;
HSV-1? gingivostomatitis, corneal keratitis (blindess)
HSV 2? genital herpes
Reactivation may occur repeadetly with or without symptoms.
VZV
Transmitted by ___ aerosols, disseminates ____, causing widepread ___ or localized ____ and epidermal blisters (aka ___). Evades IR and establishs latency in __ ___.
Acute infection - __ __
Reactivation (shingles - herpes zoster)
VZV
Transmitted by respiratory aerosols, disseminates hematogenously, causing widepread POX or localized epidermal blisters (aka shingles). Evades IR and establishs latency in sensory ganglia.
Acute infection - chicken pox, intraepithelial vesicles with intranuclear inclusions
Reactivation (shingles - herpes zoster)
___
___ infected cells enhibit ____ of entire cell and nucleus. Typically contains a large inclusion surrounded by a clear halo (OWL’S EYES).
Latently, infects ___ and their bone marrow progenitors.
Reactivated when IS is compromised.
Evades IS by down-modulating MHC I and II molecules
Acute transient infections elivist effective immune responses that eliminate the pathogens, limiting the duration of infection. They do/do not go into latency phases.
An example is ___.
Measles
Measles are characterized by what kind of cells?
What do they look like and where are the found?
How are measles confirmed?
Warthin-Finkley giant multinucleared cells. They are a grape-like cluster of nuclei found in hyperplastic lymph nodes –> particularly in LUNGS.
Confirmation of measles of rash, WFMC and Koplik spots.